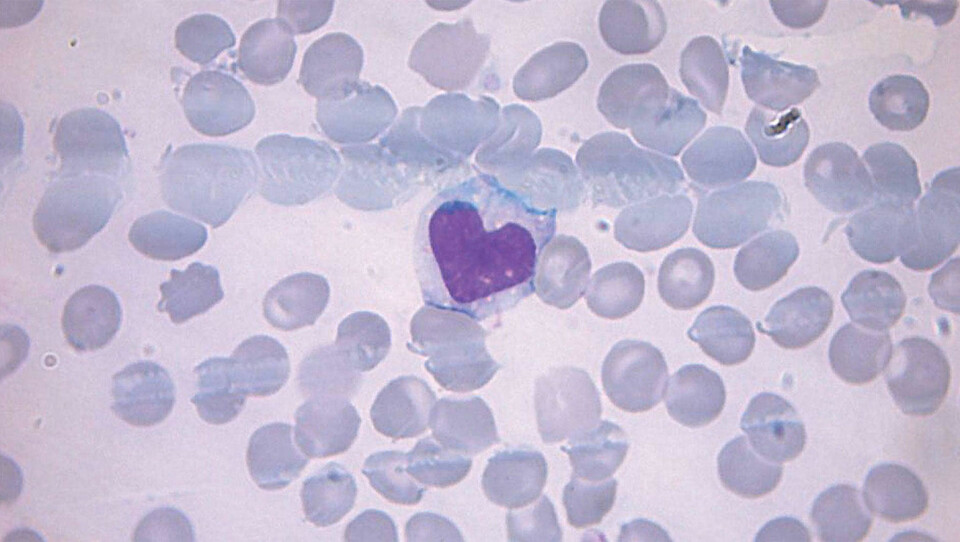

Slik ser influensa ut
Bioingeniører viser frem sykdommer i ny kalender.

Med tolv vakre mikroskopibilder vil bioingeniørene i Nito skape oppmerksomhet om jobben de gjør.
Julegaven deres til stortingsrepresentantene og lederne for landets helseforetak, er en kalender som skal minne om jobben deres.
Kalenderen er en del av Nitos kampanje for å løfte frem det de kaller de hemmelige ingeniørene i helsevesenet.
Les også: Dette er Norges mektigste teknologer
SE MER: Du finner flere bilder på tu.no
Legens øyne
Bildene i kalenderen er tatt av bioingeniører på helseforetak over hele landet. Fotografiene viser alt fra neglsopp og streptokokker til svineinfluensa og kromosomer fra leukemiceller.
– Alle vet at ingeniører jobber med bygg, anlegg og IKT, men det er lite kjent at det også jobber mange tusen ingeniører i helsevesenet. Den største gruppen er bioingeniørene som blant annet tar pasientprøver på sykehusene og analyserer disse, slik at pasientene får stilt diagnose og får riktig behandling, sier prosjektleder i NITO Lene Ståhl i en pressemelding.
– Uten bioingeniøren opererer legen i blinde, sier Ståhl, som selv er bioingeniør.

Les også: Disse studiene garanterer jobb
Kan bli bioingeniørmangel
Nito organiserer totalt rundt 6400 bioingeniører.
Organisasjonen ønsker blant annet å løfte frem bioingeniørene i bevisstheten til politikere og sykehusledelse.
De ønsker også at ungdom skal bli interessert i bioingeniøryrket, for å sikre fremtidig rekruttering. Ifølge organisasjonen viser fremskrivninger fra SSB at det vil bli mangel på bioingeniører i fremtiden.
Denne saken er først publisert på tu.no. Les også:
Flere toppledere er teknologer
Disse superelevene forgudes av Norges mektigste